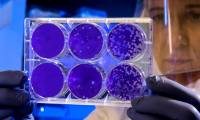
The artificial neural network found that antibiotics kill bacteria that every other drug has to give up, posing more difficult questions for science

- Himalayan vegetation is expanding rapidly, is this a good sign or the beginning of a disaster?

Recent studies show that the snow-white plateau in the Himalayas is gradually being turned green by the growth of vegetation, which looks like a good signal, but is this really
- Because of the Covid-19 epidemic, more than 100 scientists were trapped on icebreakers between the Arctic Ocean

It is likely that they will have to extend the study trip for another 6 weeks to be allowed to return.
- The little known origin of the N95 respirator

The N95 respirator, one of the most important medical protective devices available today, has undergone a complete development and development history spanning more than a century.
- The reason why the visual effects are always green and 9 filmmakers' secrets that the audience did not know

Filmmakers also face a lot of difficulties, and they have their own tricks to overcome them.
- What is a ventilator that every country in the world is racing to have as much as possible?

The most effective 'tool' to save a patient's life from the 'enemy' Covid-19 at the present time.
- How did the 5 worst pandemics of human history end?

Here are five of the most terrible pandemics in human history and how they ended with the introduction of disease prevention measures.
- Bizfly Chat: Single closing chatbot will help thousands of businesses survive the Covid-19 season

The consulting chatbot was first launched by VCCorp with the message: 'Lifetime free, store up to 10,000 subscribers, the feature is equivalent to a paid package worth 3 million /
- Facts about the Wombat species that not everyone knows

Wombat, also known as the topless koalas, is a family of mammals in the set of Two front teeth. This family was described by Burnett in 1829. Barefoot koalas are short, muscular
- The only place on Earth where Covid-19 has not been 'gone': Without corona virus, you cannot leave the house!

At the moment, this is considered the safest place in the world because there is no contact outside and far from every residential area.
- Evidence explains why 'Limiting social exposure' is an extremely important step to saving the world from the Covid-19 pandemic

At present, we do not yet have a vaccine that is safe and effective, and we do not know what is a good treatment for Covid-19. Without both of these things, the best option for us
- Wuhan team: 3-10% of Covid-19 patients after discharge were positive for the virus but did not infect others.

To clarify whether or not Covid-19 patients were 're-infected with the virus' after discharge from hospital, doctors in Wuhan conducted a number of studies.
- Japan introduces new prototype super speed train: Using wireless charging technology, reaching a maximum speed of over 500km / h

It is expected that this super-speed train will be officially put into operation on the Tokyo - Nagoya route in 2027.
- See this series of aerial photos to see how the world has changed dramatically because of COVID-19

The series of comparative pictures taken by SkyStat satellite of Planet Labs Inc will give us the incredible difference of the world when social isolation measures are applied.
- The artificial neural network found that antibiotics kill bacteria that every other drug has to give up, posing more difficult questions for science

The power of computing takes medicine to the next level.
- Mitsubishi Heavy Industries ZSX - New generation 'air conditioner'

ZSX is an air conditioner with many outstanding advantages of Mitsubishi Heavy Industries Corporation (MHI) - Heavy industry group from Japan.
- Scientific research: Life can exist in many places in the Universe, it is not only in the region we can observe.

Perhaps we are not the only intelligent creatures in the universe, but it seems the chances of finding aliens are very vague.
- How do paleontologists calculate the weight of a dinosaur?

The one thing many people always wonder is that we only found fossils of dinosaurs, but paleontologists have always been able to calculate their weight, so how did they do that? ?
- The largest mammoth structure ever found in Russia, shows that prehistoric humans are probably wiser than we thought.

The excavation of this work shows that, instead of just following the trail of animals to hunt and gather, the people in the Pleistocene period were able to build architectural
- Louis Vuitton purchased 40 million masks of COVID-19 for France

The number of cases in this country is growing exponentially, and rapid precautions are needed!
- Scientists find the true cause of the giant animal extinction in Australia

50000 years ago, the Australian continent still had many different beasts, but they disappeared in a short period of time, leaving a mystery for humankind.
 Recent studies show that the snow-white plateau in the Himalayas is gradually being turned green by the growth of vegetation, which looks like a good signal, but is this really
Recent studies show that the snow-white plateau in the Himalayas is gradually being turned green by the growth of vegetation, which looks like a good signal, but is this really It is likely that they will have to extend the study trip for another 6 weeks to be allowed to return.
It is likely that they will have to extend the study trip for another 6 weeks to be allowed to return. The N95 respirator, one of the most important medical protective devices available today, has undergone a complete development and development history spanning more than a century.
The N95 respirator, one of the most important medical protective devices available today, has undergone a complete development and development history spanning more than a century. Filmmakers also face a lot of difficulties, and they have their own tricks to overcome them.
Filmmakers also face a lot of difficulties, and they have their own tricks to overcome them. The most effective 'tool' to save a patient's life from the 'enemy' Covid-19 at the present time.
The most effective 'tool' to save a patient's life from the 'enemy' Covid-19 at the present time. Here are five of the most terrible pandemics in human history and how they ended with the introduction of disease prevention measures.
Here are five of the most terrible pandemics in human history and how they ended with the introduction of disease prevention measures. The consulting chatbot was first launched by VCCorp with the message: 'Lifetime free, store up to 10,000 subscribers, the feature is equivalent to a paid package worth 3 million /
The consulting chatbot was first launched by VCCorp with the message: 'Lifetime free, store up to 10,000 subscribers, the feature is equivalent to a paid package worth 3 million / Wombat, also known as the topless koalas, is a family of mammals in the set of Two front teeth. This family was described by Burnett in 1829. Barefoot koalas are short, muscular
Wombat, also known as the topless koalas, is a family of mammals in the set of Two front teeth. This family was described by Burnett in 1829. Barefoot koalas are short, muscular At the moment, this is considered the safest place in the world because there is no contact outside and far from every residential area.
At the moment, this is considered the safest place in the world because there is no contact outside and far from every residential area. At present, we do not yet have a vaccine that is safe and effective, and we do not know what is a good treatment for Covid-19. Without both of these things, the best option for us
At present, we do not yet have a vaccine that is safe and effective, and we do not know what is a good treatment for Covid-19. Without both of these things, the best option for us To clarify whether or not Covid-19 patients were 're-infected with the virus' after discharge from hospital, doctors in Wuhan conducted a number of studies.
To clarify whether or not Covid-19 patients were 're-infected with the virus' after discharge from hospital, doctors in Wuhan conducted a number of studies. It is expected that this super-speed train will be officially put into operation on the Tokyo - Nagoya route in 2027.
It is expected that this super-speed train will be officially put into operation on the Tokyo - Nagoya route in 2027. The series of comparative pictures taken by SkyStat satellite of Planet Labs Inc will give us the incredible difference of the world when social isolation measures are applied.
The series of comparative pictures taken by SkyStat satellite of Planet Labs Inc will give us the incredible difference of the world when social isolation measures are applied. The power of computing takes medicine to the next level.
The power of computing takes medicine to the next level. ZSX is an air conditioner with many outstanding advantages of Mitsubishi Heavy Industries Corporation (MHI) - Heavy industry group from Japan.
ZSX is an air conditioner with many outstanding advantages of Mitsubishi Heavy Industries Corporation (MHI) - Heavy industry group from Japan. Perhaps we are not the only intelligent creatures in the universe, but it seems the chances of finding aliens are very vague.
Perhaps we are not the only intelligent creatures in the universe, but it seems the chances of finding aliens are very vague. The one thing many people always wonder is that we only found fossils of dinosaurs, but paleontologists have always been able to calculate their weight, so how did they do that? ?
The one thing many people always wonder is that we only found fossils of dinosaurs, but paleontologists have always been able to calculate their weight, so how did they do that? ? The excavation of this work shows that, instead of just following the trail of animals to hunt and gather, the people in the Pleistocene period were able to build architectural
The excavation of this work shows that, instead of just following the trail of animals to hunt and gather, the people in the Pleistocene period were able to build architectural The number of cases in this country is growing exponentially, and rapid precautions are needed!
The number of cases in this country is growing exponentially, and rapid precautions are needed! 50000 years ago, the Australian continent still had many different beasts, but they disappeared in a short period of time, leaving a mystery for humankind.
50000 years ago, the Australian continent still had many different beasts, but they disappeared in a short period of time, leaving a mystery for humankind.